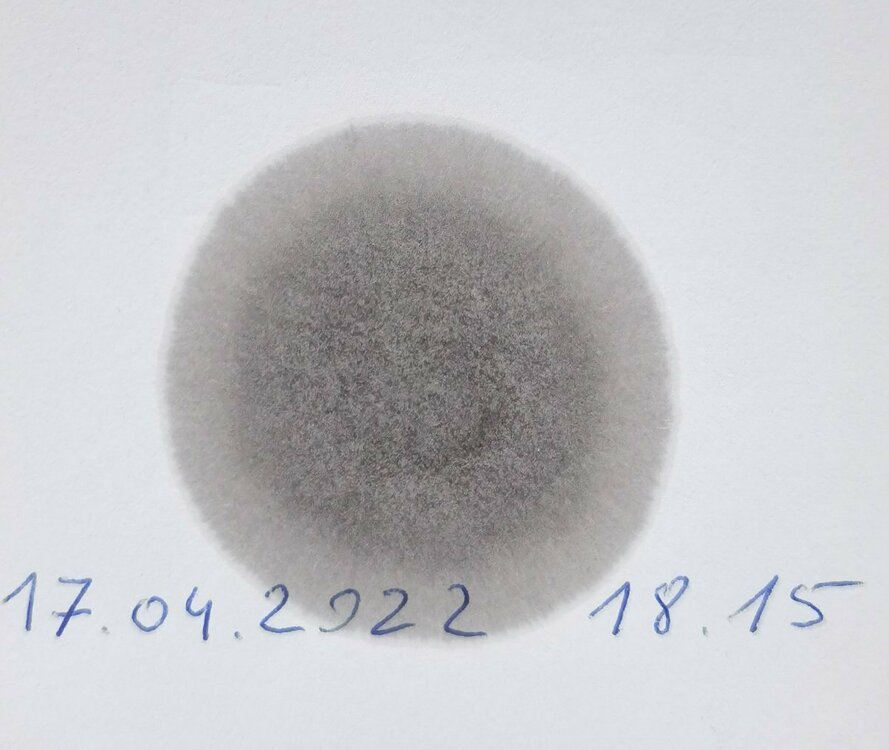
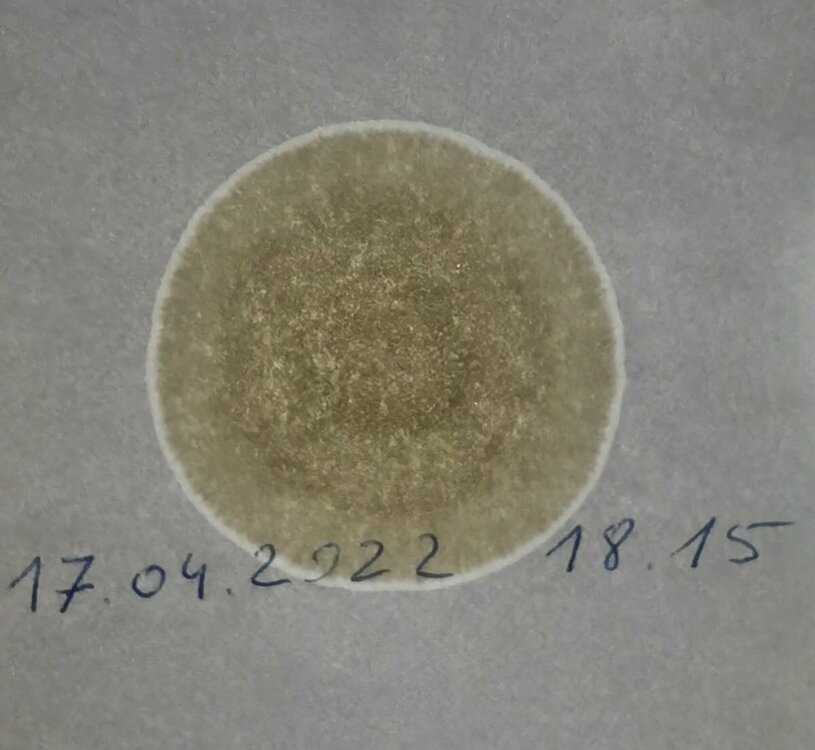

-
Sporočil
15.526 -
Z nami že
-
Nazadnje prisoten
-
Dnevne zmage
75
Tip vsebine
Profili
Forumi
Koledar
Garaže
Vse objave uporabnika Deeyan
-
pa normalno, tak ko zej 6-ko, večino AC 140km/h. 6ica pa tut bla poraba prej na letnih gumah 9.3 zej je okrog 8 (oboje gledano po računalniku)
-
pa načeloma ni blo težav z dpf-jem, dal sem ga takrat odstranit, da je avto lažje dihal.
-
poraba.com - poraba goriva, Mazda 3 CD110 PORABA.COM Mislim, da se mora gledat od 28.12.2012 naprej brez dpf, vnosov pa ni neki velik, pol sem pa avto tak prodal. U glavnem nikol prej nism prsu pod 6 litrov.
-
Ti pa js iz svojih povem, isto pri Mazdi 3 1.6 CD110 cel liter razlike, ko sm butnu dpf ven. Je pa res, da mam bolj ko ne skoz avtocestne fure
-
Vrjames al pa ne, cel liter je razlike
-

Analiza olja z metodo kapljičnega vzorca
Deeyan je odgovoril na Aless-ovo teme v forumu Tehnične težave, vzdrževanje in stroški
-
žica pa polprevodnik ja... 🤣 Najbrž je mislu na led luči, ki so na novejših prikolicah, če ma pa starejšo prikolico si jih je pa mogoče sam zmontiral
-
Tut js 🙅♂️
-
-
Tole mi zgleda kot neka manjsa ujeda (kot postovka) 😳
-
Ceprav, da ti povem, da kolker folka poznam, u nasih koncih velik folka pije union, na delu cez trojane proti Lj pa Lasko, zdej mi pa razlozi 😁
-
Kaj sele, da najdes 2 😂
-

Dober servis za Mazdo (uradni, neuradni,...)
Deeyan je odgovoril na Peter22-ovo teme v forumu Tehnične težave, vzdrževanje in stroški
Se pravi, da sm dejansko prsparu 300€ za tole 😳 noro -
sej so mišljene minimaistično
-
te forumske nalepke je ponavadi že ajvar daju tiskat, zdej pa nvem kok je kej s tem še dela to al ne tuki vas je nekaj dalo pobudo za te naše nalepke iz skupine, zarad tega sem tut naredu to temo... je pa v planu kasneje tut izdelava hoodijev z našim logotipom + ostali promocijski material
-
pa mam že cel čas napisano v podpisu 🤣
-
Tole ne gre za forumske nalepke in je zadeva čisto neobvezujoča. Takšno je ime skupine na facebooku že od leta 2009 in ga zaradi prepoznavnosti ne bomo spreminjali. Nekateri so podali željo za nalepke s tem namenom se je odprla tema na forumu, če bo sploh dovolj interesa, drugače pač nebomo šli v to, ker za (napamet govorim) 3 nalepke se ne splača. Bom pa upošteval željo za črno belo izvedbo, pa prilimam kok bi zgledalo.
-
aja, pa tisto rumeno je treba odmislit.
-
ta motiv je naš logotip, zato za1x samo takšni
-
Kolko bi vas blo interesentov za nalepke? Cena se bo gibala okrog 3€ na kos, izgledale pa bojo nekako takole
-
Kaj sele v kolenu 😂
-
preklete luknje v zakonih😡
-
ti pa nimaš sreče 😕
-
ne mislit, da mladih nemore infarkt... Reprezentant doživel infarkt WWW.ZURNAL24.SI Nova žalostna novica iz sveta nogometa.
-
Nesmes nas vse v isti kos dajet 😖

.jpg.6fedb4b5b17266ed1f02c3ee21961a40.jpg)